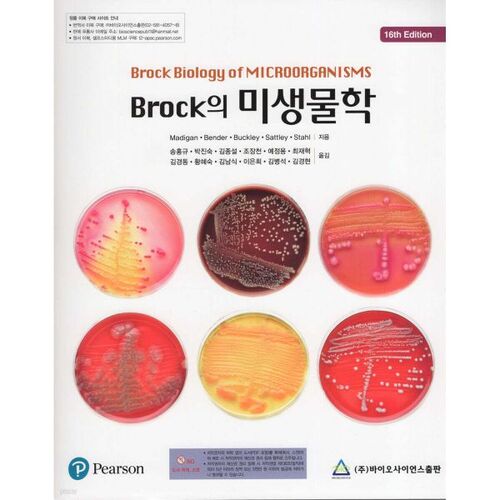
Microbiologie de Brock

Manuels universitaires
카테고리
Langue coréenne


Langue coréenne
-
Guide de formation sur le terrain -
Les mathématiques discrètes à l'ère de l'intelligence artificielle -
écologie -
hydroponique -
Compréhension et application des lois sur le réaménagement et la reconstruction -
Gestion et pratique des agences de voyages -
Construction DX -
Introduction et pratique de la technologie de certification des aéronefs -
Conférence sur le financement politique à l'intention des politiciens -
Droit successoral -
Enregistrement des relations familiales de Story -
Une approche systématique des méthodes de la théorie ancrée -
Concert de restauration écologique 2 -
Explication et jurisprudence de la loi sur la confiscation des avoirs corrompus -
Microbiologie de Brock -
Exercices de base de coupe de cheveux -
Médecine du travail et de l'environnement -
Entrepreneuriat et startups -
Introduction au droit civil -
Théorie d'Ezi Sang Han -
étude à sujet unique -
Études de cas en thérapie par le jeu -
Théorie musicale universitaire -
Comprendre la psychothérapie dynamique à long terme

![ELLE 엘르 스페셜 에디션 A형 : 12월 [2025]](http://librairie.coreenne.fr/cdn/shop/files/b8e27a3de6c9538896439686c6b0e8fb.jpg?v=1766436872&width=3840)